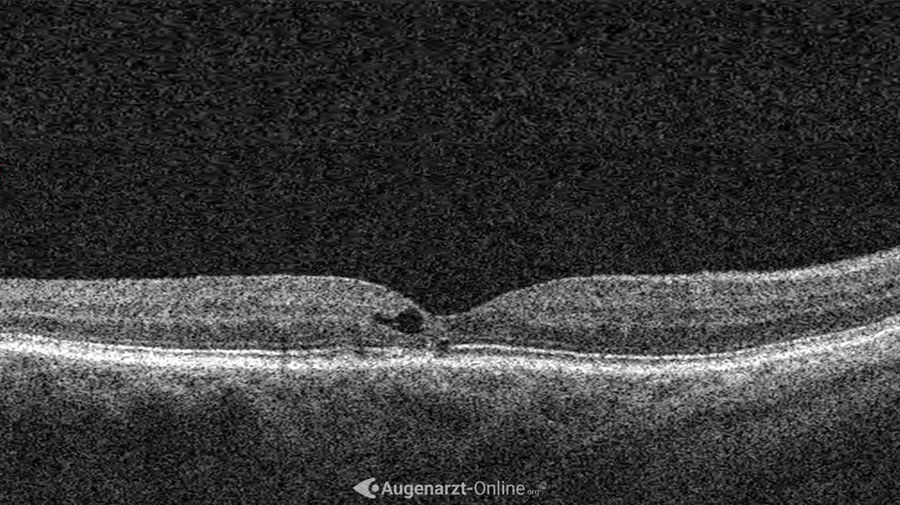

⠀
Teleangiektasien
⠀
Bei makulären Teleangiektasien kommt es zur abnormalen Bildung von Gefäßen in der Makula. Oftmals sind diese mit einer Sehverschlechterung assoziiert.
⠀
⠀
⠀
Das Wichtigste auf einen Blick
⠀
Das Wichtigste auf einen Blick
Definition
Abnormale Gefäßbildung im Bereich der Makula
Symptome
Sehverschlechterung, Metamorphopsien
Diagnostik
Spaltlampenuntersuchung, OCT, FAG
Therapie
Verlaufskontrollen, Laserkoagulation, VEGF Inhibitoren
⠀
⠀
Teleangiektasien - Definition
⠀
Makuläre Teleangiektasien („tele“ = „weit“, „angeion“ = „Gefäß“, „ektasis“ = „Ausdehnung“) beschreiben das Auftreten von abnormalen Gefäßen im Bereich der Stelle des schärfsten Sehens (Makula).
⠀
⠀
iD01_InhaltHinweis
⠀
⠀

⠀
⠀
Teleangiektasien - Symptome
⠀
Makuläre Teleangiektasien führen bei Betroffenen zu verzerrtem Sehen (Metamorphopsien). Diese können auch durch Sehhilfen nicht korrigiert werden.
Auch ein „Verschwommenes Sehen“ oder Einschränkungen im Sehzentrum (z.B. beim Erkennen von Gesichtern können auftreten. Je nach Schweregrad kann es zu einer leichten bis schweren Sehverschlechterung kommen.
⠀
⠀
iD01_InhaltHinweis
⠀
⠀

⠀
⠀
Teleangiektasien – Ursachen & Risikofaktoren
⠀
Die häufigsten Ursachen für die Entstehung von makulären Teleangiektasien sind ein Bluthochdruck (Hypertonie), mehr als die Hälfte der Fälle, sowie Blutzuckerkrankheit (Diabetes Mellitus) bei etwa einem Drittel der Betroffnen. Aber auch in Folge von Krankheiten kann es zur Bildung von Teleangiektasien kommen.
Außerdem werden makuläre Teleangiektasien manchmal als Variante eine Morbus Coats interpretiert.
Man unterscheidet folgende Typen:
Typ 1: aneurysmatische Teleangiektasien
Typ 2: perifoveale Teleangiektasien
⠀
⠀
iD01_InhaltHinweis
⠀
⠀

⠀
⠀
Teleangiektasien - Diagnostik
⠀
Spaltlampenuntersuchungen
Oftmals können Teleangiektasien bereits in der Untersuchung mit der Spaltlampe festgestellt werden. Bei idiopathischen makulären Teleangiektasien, kommt es zu einer Erweiterung der Kapillaren der Macula. Diese können als punktförmige rote Flecken identifiziert werden. Teleangiektasien Typ 1 treten meist einseitig auf, führen zu harten Exsudaten und zeigen ein zystoides Makulaödem mit peripheren Teleangiektasien („Coats“-Typ). Teleangiektasien Typ 2 treten hingegen meist beidseitig auf und sind im Rahmen der Spaltlampenuntersuchung kaum zu erkennen.
Optische Kohärenztomographie (OCT)
Im horizontalen Schnitt zeigen sich makuläre Teleangiektasien als hyporeflektierende Hohlräume. Diese befinden sich im Inneren der Netzhaut und sind oft von einem leicht hyperreflektierenden Rand umgeben. Oftmals kommt es zu Disruptionen der darunterliegenden Photorezeptoren.
Fluoreszenzangiographie (FAG)
In der Fluoreszenzangiographie zeigen sich makuläre Teleangieektasien als kleine hypofluoreszierende Stellen, Die mit den punktförmigen roten Flecken in der Spaltlampenuntersuchung übereinstimmen.
⠀
⠀
iD01_InhaltHinweis
⠀
⠀

⠀
⠀
Teleangiektasien - Therapie
⠀
Idiopathische Teleangiektasien beim Erwachsenen benötigen in der Regel keine Therapie, sondern müssen in regelmäßigen Abständen kontrolliert werden. Kommt es jedoch zu einer Sehverschlechterung, so muss eine fokale Laserkoagulation erwogen werden. Hierbei ist jedoch ein ausreichender Abstand zur Fovea notwendig.
Periphere Teleangiektasien, die im Rahmen eines Morbus Coats auftreten, sollten frühzeitig durch Laserkoagulation oder Kryokoagulation verödet werden. Ein früher Therapiebeginn führt zu einer Rückbildung der Exsudate und erhöht die Chancen auf einen Erhalt der Sehkraft.
⠀
⠀
iD01_InhaltHinweis
⠀
⠀

⠀
⠀
Teleangiektasien - Gallerie
⠀
⠀
⠀
iF01_Video
⠀
⠀
⠀
⠀
⠀
⠀
⠀
Rechtshinweis: Diese Seite enthält nur allgemeine Hinweise und darf nicht zur Selbstdiagnose oder Selbstbehandlung verwendet werden. Sie kann einen Arztbesuch nicht ersetzen.
⠀
Augenarzt - Suche
Finde jetzt einen Augenarzt in deiner Nähe. Gib einfach deine Postleitzahl oder deinen Ort ein und los geht‘s!